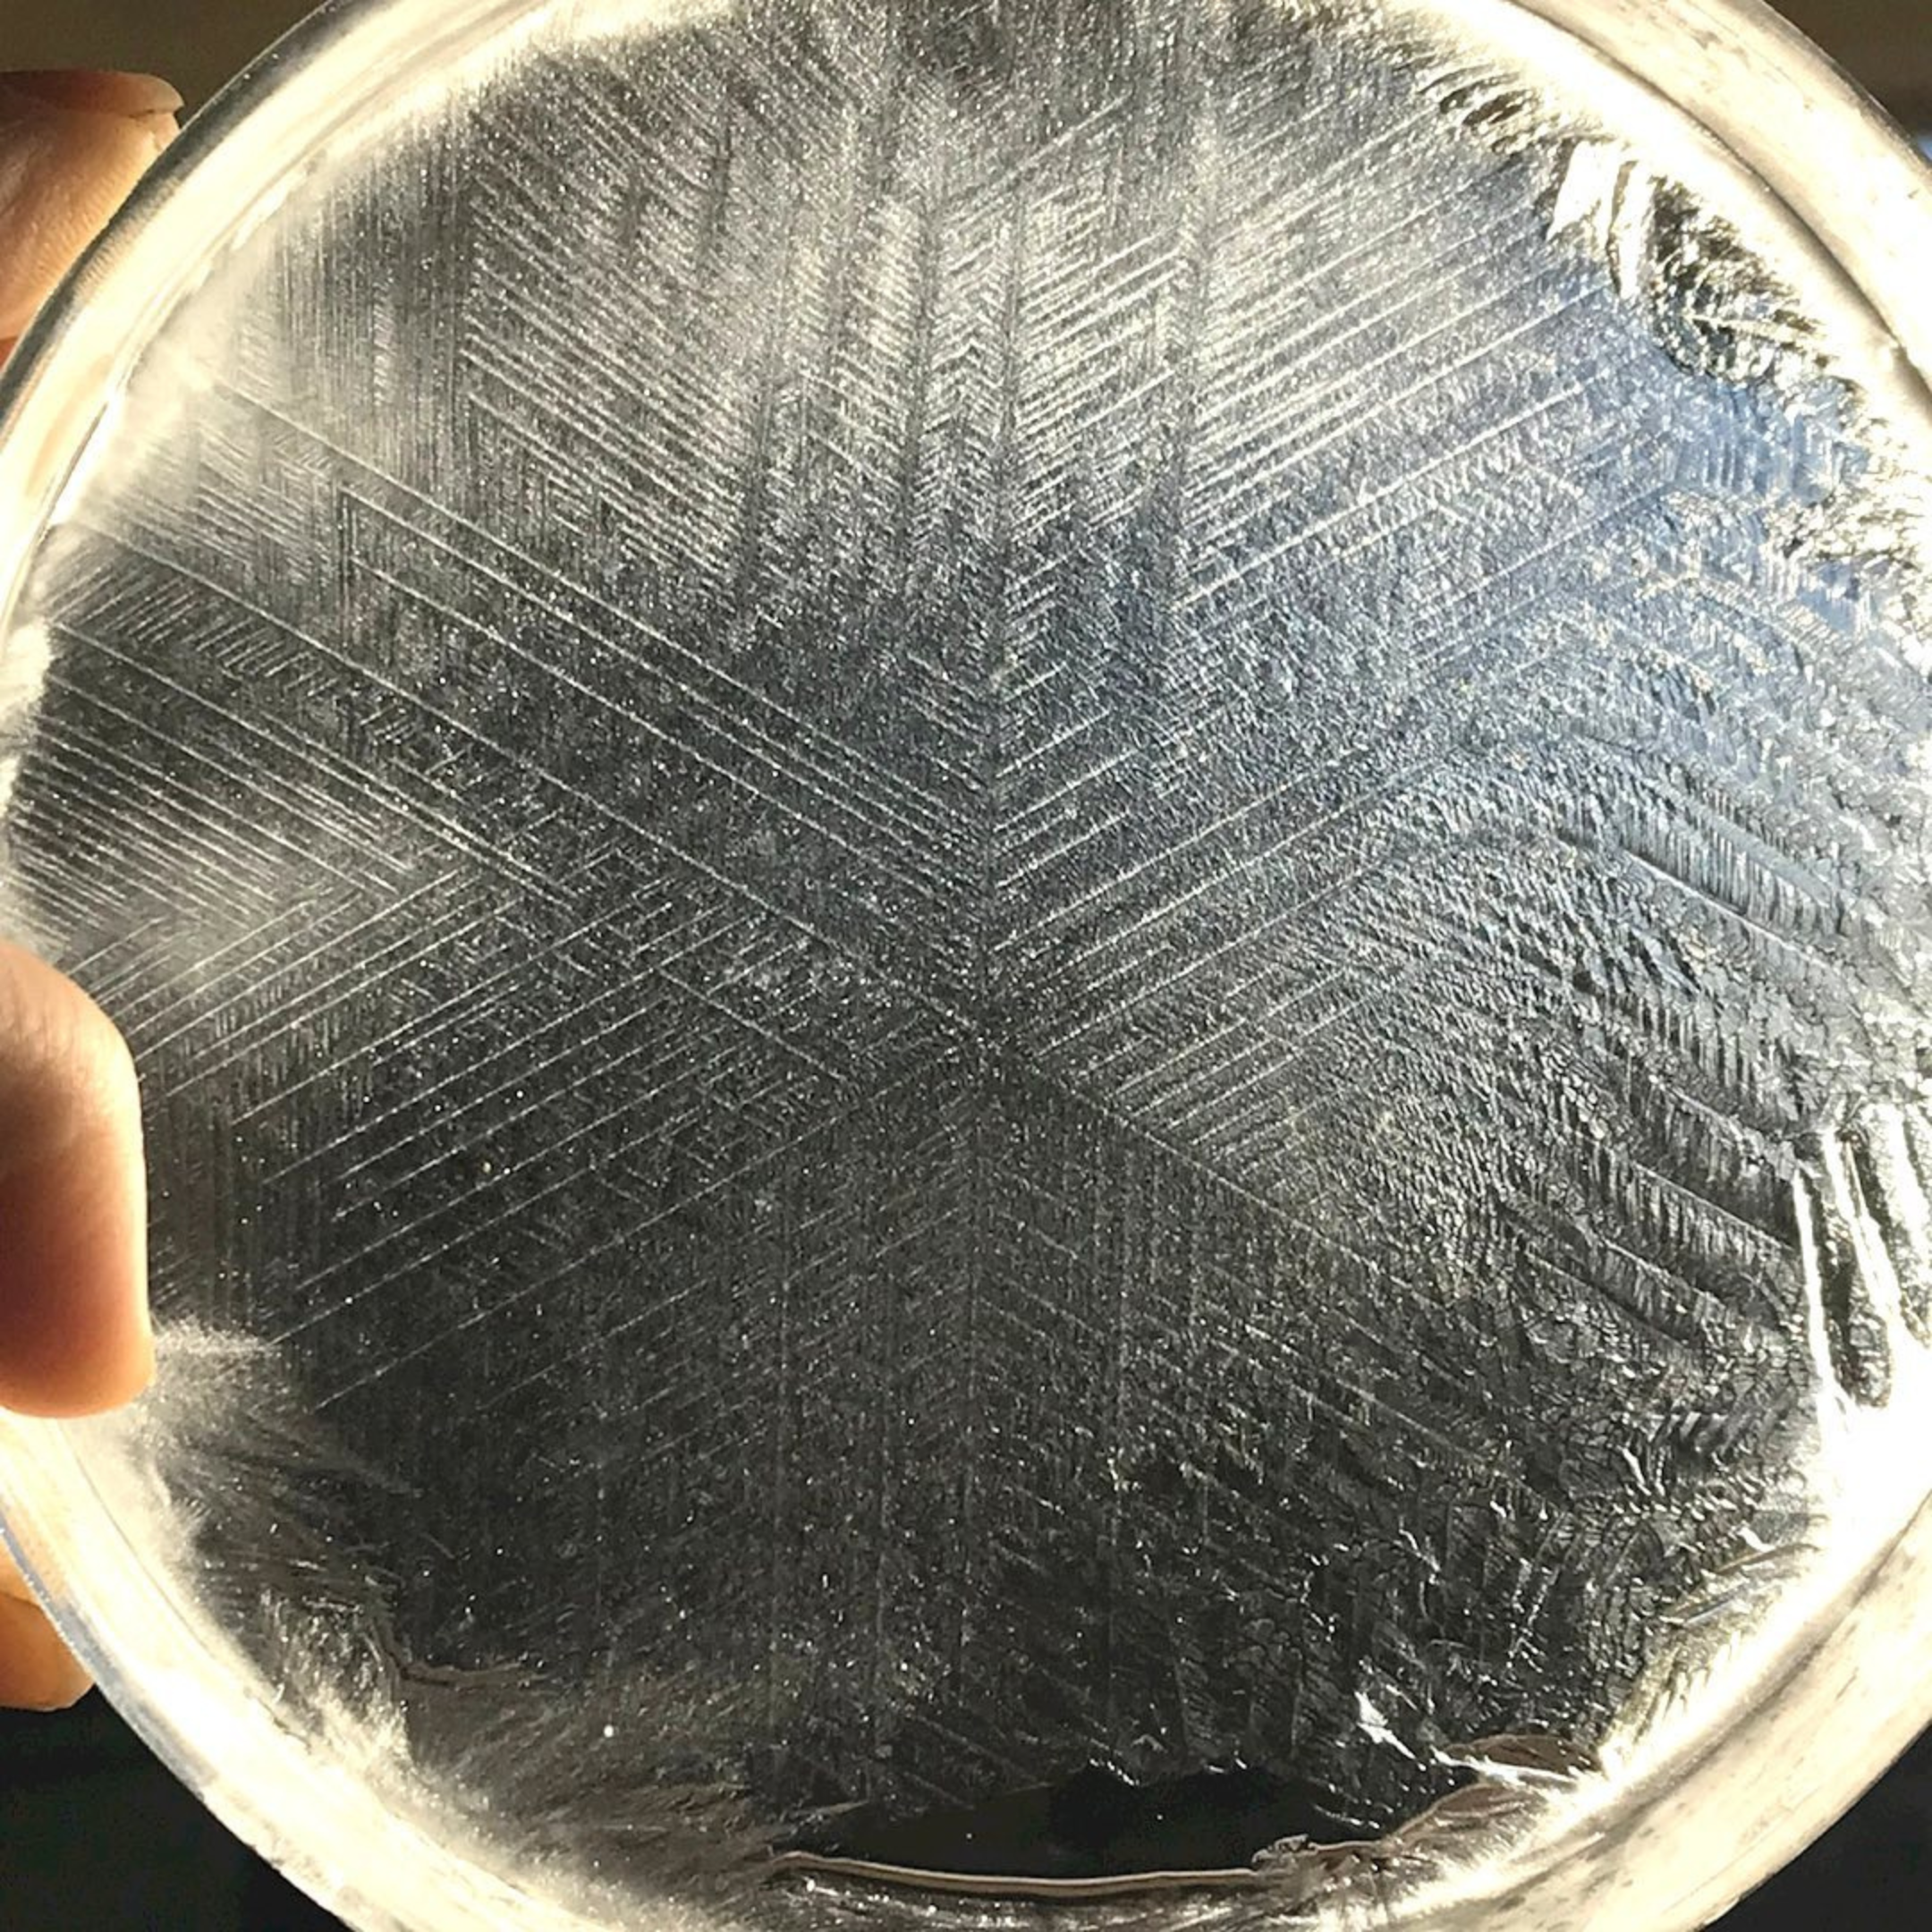

The Crux of the Matter ~ The role of the Southern Cross and the closing of a galactic circuit (REPLAYS)
The Crux of the Matter ~ The role of the Southern Cross and the closing of a galactic circuit (REPLAYS)
YOU ARE PURCHASING ACCESS TO THE REPLAYS
A 3-part Virtual Series
Hānaiakamalama
CRUX
Part 1.
the star lineages
The 6 directions
Part 2.
the Atlantean time-line
composition of the “challenging of love”
Part 3.
Crux completes the circuit
The Hexagon is Accomplished
Human Consciousness is coded in the HEXAGON. We are fashioned from 6 star lineages, 6 directions, 6 elements. Is CRUX, the southern cross, our 6th, and final, lineage? Will CRUX close the circuit of human consciousness, and complete the Human Event?
Join Pōhala founder Ke’oni Hanalei as he delves into the intricate and sophisticated star lineages, retrieving long-held knowledge preserved in the Mū and Ē (Atlantean) doctrines. The number 6, and the recurring presence of the hexagon, are crucial for decoding the true design of the electrical galactic circuit that shapes human experience. Logistically, Earth and our sun, Apsu Lā, form a convergence point for six distinct star lineages that contribute experiments and “directions” we must enact to fulfill the human event. We can trace and decipher five of these with confidence — DRACO, ARCTURUS, SIRIUS, PLEIADES, and LYRA — while the sixth remains elusive. Could the 6th star lineage be CRUX, Hānaiakamalama? If so, Crux would hold the codes needed to complete the galactic circuit and thereby qualify the fulfillment of the human event. In that moment the circuit would close and we would exult as alpha/omega. That would also imply Crux contains the actual sixth element, and this element would reveal the processes and outcomes inherent in an authentic alpha/omega occurrence. HUGE!
Featuring guest speaker NATASHA KEALOHA
Crystallography of the primary waters, iwi hilo wai, that exhibit the hexagon. The pure primary waters have archived the most fundamental design, the 6, disclosing to us that there are actually 6 directions, 6 worlds, 6 ELEMENTS, and 6 lineages that constitute the completion of the Human Experience. As we reunite with our 6th, we get closer to the exultation of humanity, of our universe, and of TIME itself.
*photo curtesy of VEDA AUSTIN
What to expect
CEREMONIES ARE HOSTED VIA ZOOM
ALL CEREMONIES will be RECORDED with REPLAY access granted to all whom register, you DO NOT NEED to attend any of the ceremonies LIVE
UPON REGISTRATION, your email will be added to our group newsletter. Newsletters will be emailed to all registrants before each ceremony as reminder AND will also be sent out post our LIVE ceremonies so that you may access the REPLAY link.
Upon completion of our entire series, you will be emailed a composite with all replay links. These links will not expire.
Ceremony 1
The Star Lineages
the 6 directions
Holy Hexagon
In our maiden voyage, let us explore the star lineages that serve as predecessors to CRUX, tracing the paths that have shaped its emergence. Each star lineage outlines particular elements, experiments, and signatures, and together they map distinct influences, tendencies, and traits. Let us carefully weave these lineages together to deepen our understanding of the organic human, its evolutionary contours, and its ongoing relationship to the wider Universe.
Key Points of Interest:
Draco, the 1st.
Arcturus, the 2nd.
Sirius, the 3rd.
Pleiades, the 4th.
Lyra, the 5th.
CRUX and the HOLY HEXAGON
what are star lineages?
Significance of the number 6
Circuit Technology and the Alpha/Omega
Ceremony 2
The Atlantean time-line, THE MATTER
composition of the “challenging of love”
Matter is our present condition, the lived form we inhabit now. This appears to be a legacy of our stellar ancestries, a response to an animate, electrically charged universe. The Atlantean timeline represents both a culmination and an achievement of Matter’s unfolding. To close the circuit, we must bring Matter to completion and fulfillment. What do the five predecessor lineages reveal about the nature and purpose of Matter? And what might the sixth lineage propose as the way to consummate or complete it?
In addition, we perceive Ē, Atlantis, to be the challenging of love. Lets explore how to honor a completion of challenging love and to once again become absorbed in love. Does the 6th lineage/element/direction give us any clues as to what or how we become “absorbed in love”?
Key Points of Interest:
What is Ē, Atlantis?
What is the “challenging of love”?
In order to achieve the 6th Element, we must complete Atlantis. How?
A universe of Matter and Animation, what does it all mean?
Ceremony 3
Crux Completes the Circuit
The Hexagon is Accomplished
If Crux, Hānaiakamalama, confirms itself as the sixth and final star lineage, what might that signify? In such a revelation we could spontaneously become aware of the true nature and quality of this sixth element. What would that sixth element mean for humanity’s exaltation? Let us also examine the subtle, beautiful nuances of the constellation Crux—the Southern Cross—its historical relevance to our ancestors, and its meaning for us now. How might a sixth direction, lineage, world, or element fulfill our galactic agreements and usher all of us into an unimaginable rebirth?
Key Points of Interest:
logistics of CRUX
history of CRUX
metaphors of CRUX
the protocol of the elements
at a time of the closing of a galactic circuit
Featuring our amazing guest presenter, NATASHA KEALOHA
The 5 predecessors: DRACO, ARCTURUS, SIRIUS, PLEIADES, LYRA
The presumed 6th Lineage, and host of the 6th ELEMENT, CRUX
a mention on Authority…
We all have the inherent authority to share what we know and remember, and even what we imagine. For me, everything I share, proliferate, expose, and express is also supported by 20,000 years of ancestral legacy. My relative, Mahat, who lived in 18,000BC, curated and enforced a sophisticated software of archiving the human condition. My family have preserved this precious line. This line, to which I have access, has been uncorrupt, and undisturbed for over 1,017 generations. I am very confident in my approach to share these archives, with the goal to activate your own. I truly feel that I not only have access to this archive, I am this archive. It is by way of my inherent authority that I generously share with everything and everyone. Mahalo and ALOHA MĀ ~ Ke’oni Hanalei
If you have any questions, EMAIL us. upon registration, you will receive a digital download email to which you can access a PDF file with a full list of REPLAYS of our ceremonies.
if you have previously sojourned with us during the GENEALOGY of MŪ series, this latest series is a fine companion as we are simply extending our exploration into Atlantis as to close the circuit. If you’ve not enjoyed the Genealogy of Mū series, joining CRUX is a totally independent offering and introductory of itself. All are welcome to join!